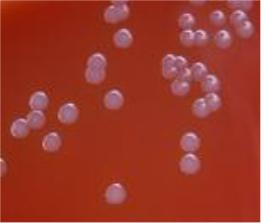

Материал: Нейссерии

21
Рисунок 24 - Менингококковые вакцины.
Вслучае возникновения хотя бы одного случая менингококковой инфекции
взамкнутом коллективе возможно проведение химиопрофилактики с применением антибиотиков (экстренная антибиотикопрофилактика).
Гонококки
Гонококковая инфекция (гонорея) - это инфекционное заболевание человека, вызываемое Neisseria honorrhoeae, которое передается половым путем и характеризуется гнойным воспалением слизистой оболочки мочеполовых путей (гонорея), конъюнктивы глаз (бленнорея) или других органов.
Возбудитель гонореи был открыт А. Нейссером (рисунок 1) в 1879 г. Этиологическую роль Neisseria honorrhoeae в развитии гонореи доказал в 1885 г. немецкий акушер-гинеколог Э. Бумм (рисунок 25).
Рисунок 25 - Эрнст Бумм (Ernst Bumm, 1858 – 1925 гг.).
Морфологические и тинкториальные свойства. Гонококки представляют собой неподвижные диплококки размером 1,25÷1,0x0,7÷0,8 мкм. У гонококков отмечается полиморфизм – в препаратах встречаются мелкие или крупные кокки, а также палочковидные формы. Хорошо окрашиваются анилиновыми красителями (метиленовым синим, бриллиантовым зеленым и др.). По Граму окрашиваются в розовый цвет, то есть являются грамотрицательными (рисунок 26).

22
Рисунок 26 - Гонококки, форма клеток и окраска по Граму.
Под действием пенициллина гонококки способны образовывать L-формы: округлые образования, превышающие в несколько раз в диаметре исходные клетки (рисунок 27).
Рисунок 27 - L-формы гонококков (указаны стрелкой).
Гонококки образуют капсулу (рисунок 28), спор не образуют.
Рисунок 28 - Капсула у гонококков.
23
Культуральные свойства. Гонококки являются аэробами. Оптимальная температура - 37ОС, оптимальное значение рН - 7,2-7,4. Гонококки требовательны к питательным средам. Для их выращивания используют среды, содержащие кровь, сыворотку крови или асцитическую жидкость. На плотных питательных средах через 24 часа гонококки образуют слегка мутные или прозрачные бесцветные колонии круглой формы с ровными краями диаметром 1-3 мм, На средах с кровью гемолиза не вызывают (рисунок 29).
Рисунок 29 - Колонии гонококка на кровяном агаре.
В жидких питательных средах гонококки растут диффузно и образуют поверхностную пленку, через несколько дней оседающую на дно.
Биохимическая активность гонококков крайне низкая. Они разлагают только глюкозу с образованием кислоты без газа, продуцируют каталазу и цитохромоксидазу. Протеолитическая активность отсутствует, аммиака, сероводорода и индола не образуют.
Резистентность. Гонококки очень неустойчивы во внешней среде. При температуре 56ОС они погибают в течение 5 минут, при 100ОС - мгновенно. Гонококки чувствительны к действию многих антисептиков и дезинфектантов. Высокочувствительны ко многим антибиотикам, в том числе к пенициллинам. В последнее время получили распространение штаммы, устойчивые к сульфаниламидам и антибиотикам. Штаммы, устойчивые к пенициллину, продуцируют β-лактамазы, синтез которых обусловлен R-плазмидами.
Антигенная структура. Гонококки содержат следующие антигены:
-соматический антиген;
-капсульный антиген;
-липоолигосахарид (ЛОС);
-антигены пилей;
-белки наружной мембраны.
Среди антигенов гонококков основная роль принадлежит антигенам пилей и белкам наружной мембраны. Пили состоят из белковых субъединиц, остатков сахаров и фосфорной кислоты. Последовательность соединения белковых субъединиц пилей может меняться, в результате чего изменяются антигенные свойства клеток. Наружная мембрана содержит протеины разных классов. Эти протеины проявляют сильные иммуногенные свойства. По составу протеинов

24
наружной мембраны выделяют несколько серотипов гонококков. Антитела к протеинам клеточной стенки в присутствии комплемента проявляют бактерицидные свойства.
Факторы патогенности гонококков:
-капсула;
-пили (фимбрии);
-липоолигосахарид (ЛОС);
-поверхностные белки наружной мембраны;
-трансфериновые рецепторы TbrA и TbrB;
-IgA-протеаза;
-рибосомальный белок.
Все свежевыделенные культуры имеют капсулу, которая состоит из полифосфатов. Капсула препятствует фагоцитозу и маскирует антигены клеточной стенки.
Пили (рисунок 30) состоят из белка пилина и обеспечивают адгезию гонококка к эпителию. Изменение структуры пилина приводит к изменению антигенного состава фимбрий. Вариабельность строения пилей способствует выживаемости гонококков на эпителиальных клетках при смене хозяина и воздействии антител. Клетки, не имеющие пилей, заболевания не вызывают. Утрата гонококками пилей называется сменой фаз роста. Смена фаз роста позволяет гонококкам отрываться от эпителиальных клеток и разноситься по организму.
Капсула
Пили
Рисунок 30 - Капсула и пили гонококков.
Липоолигосахарид (ЛОС) гонококков отличается от липополисахаридов других грамотрицательных бактерий тем, что имеет разветвленное ядро и не имеет боковой цепи (О-антигена). Липоолигосахарид способен изменять антигенный состав, что позволяет гонококкам уклоняться от воздействия иммунной системы. Он обусловливает продукцию медиаторов воспаления – цитокинов.
Поверхностный белок наружной мембраны I класса (белок РI, Por-
белок) является порином и образует каналы, пронизывающие наружную мембрану гонококков. Этот белок способствует внутриклеточному выживанию бактерий и препятствует слиянию лизосом с фагосомой. Показано, что Por-белок способен отрываться от наружной мембраны гонококков и встраиваться в мембрану

25
эпителиальных клеток человека, формируя в ней каналы. Это способствует проникновению возбудителя в эпителиальные клетки.
Поверхностный белок II класса (Ора-протеин, протеин мутности,
инвазин) способствует плотному прилеганию гонококков к эпителиальным клеткам и их инвазии внутрь клеток. Наличие этого белка обусловливает мутность колоний гонококков (например, при исследовании материала из уретры мужчин). При отсутствии этого белка колонии гонококков становятся прозрачными (в частности, при исследовании крови, синовиальной жидкости).
Расположение некоторых факторов патогенности в наружной мембране гонококков представлено на рисунке 31.
Пили
Por Opa
Рисунок 31 - Расположение факторов патогенности в наружной мембране гонококков.
Поверхностный белок III класса (Rmp-белок) осуществляет защиту гонококка от антител класса IgM.
Трансфериновые рецепторы TbrA и TbrB взаимодействуют с трансферином человека и извлекают из него железо.
IgA-протеаза расщепляет секреторный иммуноглобулин, в результате чего инактивируются местные антитела слизистых оболочек, препятствующие адгезии бактерий к рецепторам эпителиальных клеток.
Рибосомальный белок (L12-протеин) отвечает за возникновение восходящей гонореи у женщин.
Патогенез. Входными воротами для возбудителя гонококковой инфекции служит цилиндрический эпителий уретры, шейки матки, конъюнктивы и дистального отдела прямой кишки. На слизистой оболочке гонококки с помощью пилей закрепляются на поверхности эпителиальных клеток. В месте входных ворот посредством IgA-протеазы и поверхностных белков возбудитель подавляет защитные факторы организма и размножается, колонизируя эпителий (рисунок 32).